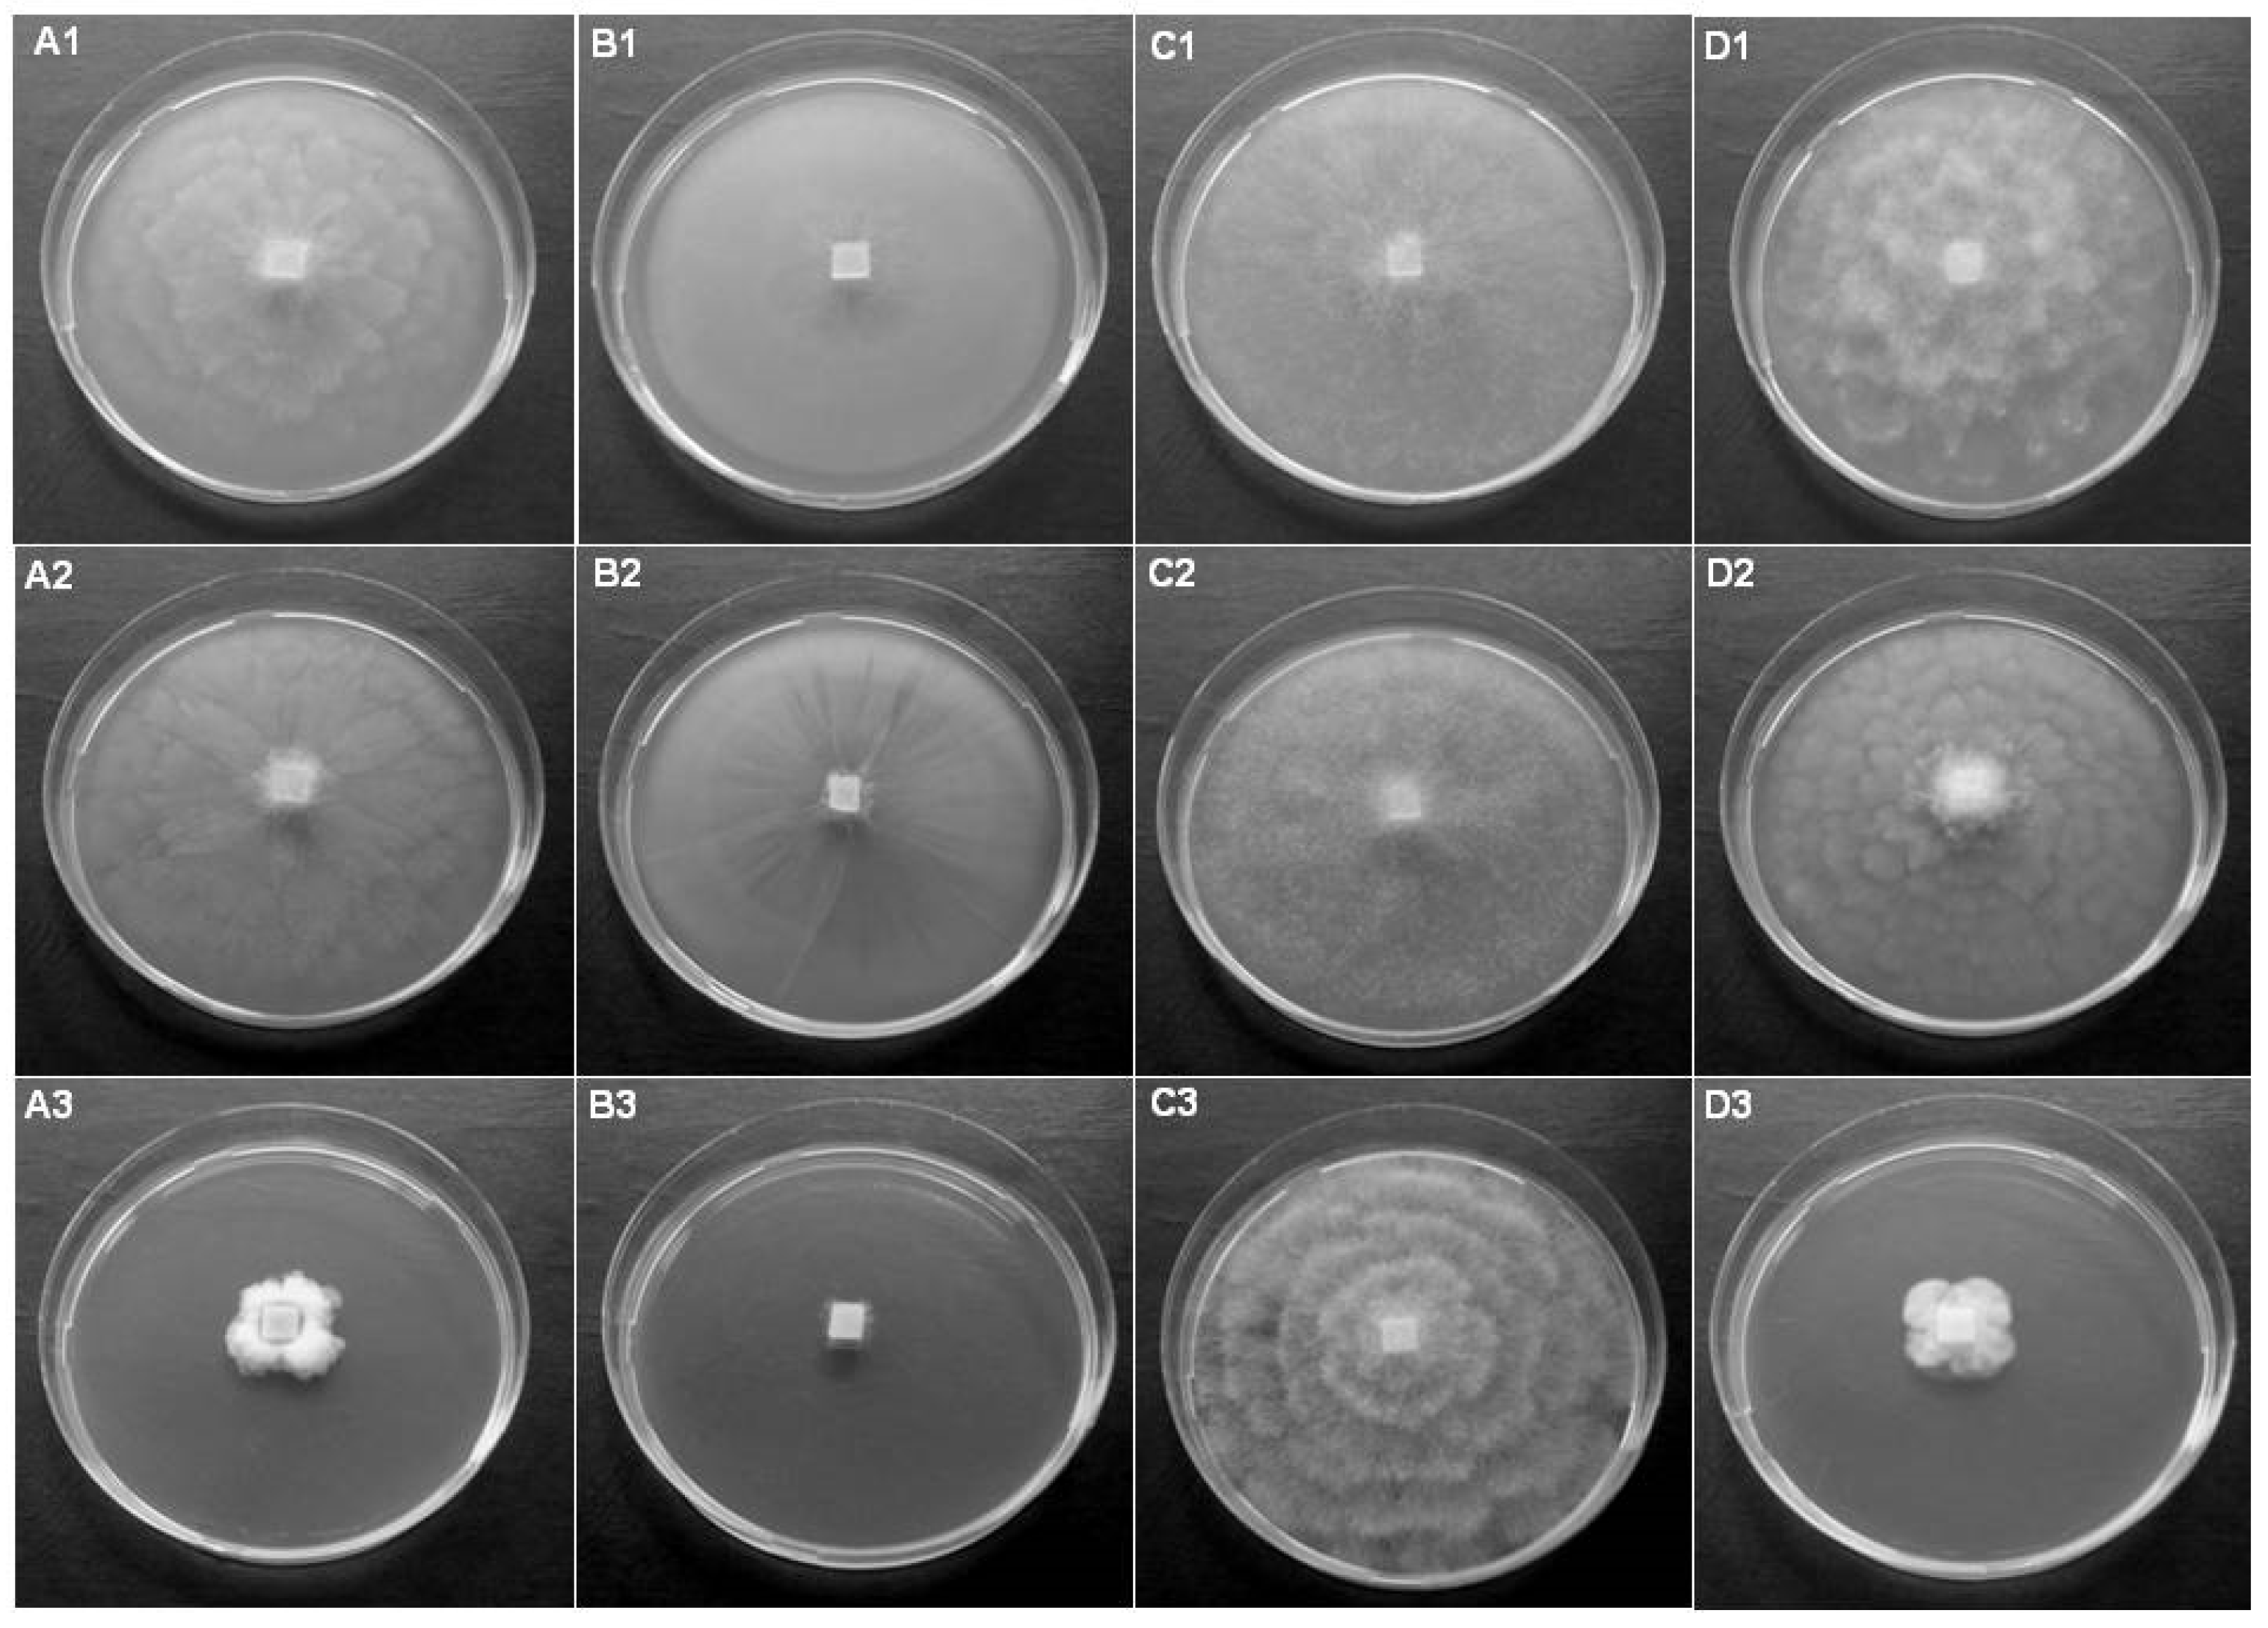
Diversity 16 00530 g002

Fishing for Estuarine Oomycetes
Abstract
1. Introduction
2. Materials and Methods
2.1. Sampling Area
- Next to a sandbar between the river and the sea—samples with numbers RVel2021/115 and RVel2021/120 (GPS coordinates: 42.066845, 27.971472). The river bottom in the region is sandy and the main vegetation is common reed (Phragmites australis).
- In the liman area of the river—samples with numbers RVel2021/114 and RVel2021/118 (GPS coordinates: 42.066310, 27.971529) and RVel2021/119 (GPS coordinates: 42.064896, 27.970419). In addition to the reed, there are grassy meadow species and dense riparian vegetation.
- In the forest area of the river—samples with numbers RVel2021/112 (GPS coordinates: 42.060125, 27.966534), RVel2021/113 and RVel2021/116 (GPS coordinates: 42.061555, 27.967234) and RVel2021/117 (GPS coordinates: 42.063026, 27.968246). There is forestry vegetation that includes alder, hornbeam, elm, ash, lianas and creeping plants.
2.2. Baiting and Isolation of Oomycetes
2.3. Species Identification
2.4. Colony Morphology
2.5. Testing for Potential Host Plants
3. Results
3.1. Diversity of Oomycetes
| No. of Isolate | Species | GenBank No. | Type of Bait | Location | Baiting Period |
|---|---|---|---|---|---|
| RVel2021/112a | P. lacustris | PQ107011 | rhododendron | 42.060125, 27.966534 | 2 May 2021 (start) 5 May 2021 (end) |
| RVel2021/112c | P. lacustris | PQ107013 | rhododendron | ||
| RVel2021/112d | P. lacustris | PQ107014 | oak | ||
| RVel2021/112f | P. lacustris | PQ107016 | oleander | ||
| RVel2021/113a | Pp. citrinum | PQ110268 | oak | 42.061555, 27.967234 | |
| RVel2021/113b | Pp. litorale | PQ107594 | oak | ||
| RVel2021/113c | E. anandrum | PQ107604 | oak | ||
| RVel2021/113d | P. lacustris | PQ107017 | oleander | ||
| RVel2021/113e | P. lacustris | PQ107019 | oleander | ||
| RVel2021/114a | P. lacustris | PQ107021 | rhododendron | 42.066310, 27.971529 | |
| RVel2021/114b1 | P. lacustris | PQ107022 | rhododendron | ||
| RVel2021/114b2 | P. lacustris | PQ107024 | rhododendron | ||
| RVel2021/114c | Py. angustatum | PQ107654 | oak | ||
| RVel2021/114d | P. lacustris | PQ107026 | oak | ||
| RVel2021/114e | P. lacustris | PQ107025 | oleander | ||
| RVel2021/114f | P. lacustris | PQ107479 | oleander | ||
| RVel2021/115a | P. lacustris | PQ107487 | rhododendron | 42.066845, 27.971472 | |
| RVel2021/115b | P. lacustris | PQ107488 | rhododendron | ||
| RVel2021/115c | P. lacustris | PQ107490 | oak | ||
| RVel2021/115d | E. anandrum | PQ107632 | oak | ||
| RVel2021/115e | P. lacustris | PQ107492 | oleander | ||
| RVel2021/116a | P. honggalleglyana | PQ107495 | rhododendron | 42.061555, 27.967234 | 16 July 2021 (start) 18 July 2021 (end) |
| RVel2021/116b | P. honggalleglyana | PQ107496 | rhododendron | ||
| RVel2021/117a | P. honggalleglyana | PQ107498 | rhododendron | 42.063026, 27.968246 | |
| RVel2021/117b | P. honggalleglyana | PQ107497 | rhododendron | ||
| RVel2021/118a | P. honggalleglyana | PQ107499 | rhododendron | 42.066310, 27.971529 | |
| RVel2021/118b | P. honggalleglyana | PQ107501 | rhododendron | ||
| RVel2021/119a | P. bilorbang | PQ107517 | rhododendron | 42.064896, 27.970419 | 9 September 2021 (start) 11 September 2021 (end) |
| RVel2021/119b | P. inundata | PQ107518 | rhododendron | ||
| RVel2021/120a | P. honggalleglyana | PQ107500 | rhododendron | 42.066845, 27.971472 | |
| RVel2021/120b | P. honggalleglyana | PQ107504 | rhododendron | ||
| RVel2021/120c | P. honggalleglyana | PQ107514 | rhododendron |

3.2. Investigation of Potential Host Plants
4. Discussion
5. Conclusions
Funding
Institutional Review Board Statement
Data Availability Statement
Acknowledgments
Conflicts of Interest
References
- Schroeder, K.L.; Martin, F.N.; De Cock, A.; Lévesque, C.A.; Spies, C.F.J.; Okubara, P.A.; Paulitz, T.C. Molecular detection and quantification of Pythium species: Evolving taxonomy, new tools, and challenges. Plant Dis. 2013, 97, 4–20. [Google Scholar] [CrossRef]
- Kageyama, K. Molecular taxonomy and its application to ecological studies of Pythium species. J. Gen. Plant Pathol. 2014, 80, 314–326. [Google Scholar] [CrossRef]
- Parke, J.L.; Redekar, N.R.; Eberhart, J.L.; Funahashi, F. Hazard analysis for Phytophthora species in container nurseries: Three Case Studies. HortTechnology 2019, 29, 745–755. [Google Scholar] [CrossRef]
- Thines, M. Phylogeny and evolution of plant pathogenic oomycetes—A global overview. Eur. J. Plant Pathol. 2014, 138, 431–447. [Google Scholar] [CrossRef]
- Oh, E.; Gryzenhout, M.; Wingfield, B.D.; Wingfield, M.J.; Burgess, T.I. Surveys of soil and water reveal a goldmine of Phytophthora diversity in South African natural ecosystems. IMA Fungus 2013, 4, 123–131. [Google Scholar] [CrossRef] [PubMed]
- Milenković, I.; Keča, N.; Karadžić, D.; Radulović, Z.; Nowakowska, J.A.; Oszako, T.; Sikora, K.; Corcobado, T.; Jung, T. Isolation and pathogenicity of Phytophthora species from poplar plantations in Serbia. Forests 2018, 9, 330. [Google Scholar] [CrossRef]
- Corcobado, T.; Cech, T.L.; Daxer, A.; Datkova, H.; Janousek, J.; Patra, S.; Jahn, D.; Huettler, C.; Milenkovic, I.; Tomsovsky, M.; et al. Phytophthora, Nothophytophthora and Halophytophthora diversity in rivers, streams and riparian alder ecosystems of Central Europe. Mycol. Prog. 2023, 22, 50. [Google Scholar] [CrossRef]
- Jung, T.; Scanu, B.; Brasier, C.M.; Webber, J.; Milenković, I.; Corcobado, T.; Tomšovský, M.; Pánek, M.; Bakonyi, J.; Maia, C.; et al. A Survey in Natural Forest Ecosystems of Vietnam Reveals High Diversity of both New and Described Phytophthora Taxa including P. ramorum. Forests 2020, 11, 93. [Google Scholar] [CrossRef]
- Nagel, J.H.; Gryzenhout, M.; Slippers, B.; Wingfield, M.J.; Hardy, G.E.S.J.; Stukely, M.J.C.; Burgess, T.I. Characterization of Phytophthora hybrids from ITS clade 6 associated with riparian ecosystems in South Africa and Australia. Fungal Biol. 2013, 117, 329–347. [Google Scholar] [CrossRef]
- Yang, X.; Hong, C.X. Phytophthora virginiana sp. nov., a high-temperature tolerant species from irrigation water in Virginia. Mycotaxon 2013, 126, 167–176. [Google Scholar] [CrossRef]
- Christova, P.; Kostov, K.; Lyubenova, A.; Slavov, S. A new hybrid of Phytophthora from Southeast Europe. Mycologia 2021, 113, 734–747. [Google Scholar] [CrossRef]
- Jung, T.; Stukely, M.J.C.; Hardy, G.E.S.J.; White, D.; Paap, T.; Dunstan, W.A.; Burgess, T.I. Multiple new Phytophthora species from ITS Clade 6 associated with natural ecosystems. Persoonia 2011, 26, 13–39. [Google Scholar] [CrossRef] [PubMed]
- Reeser, P.W.; Sutton, W.; Hansen, E.M.; Remigi, P.; Adams, G.C. Phytophthora species in forest streams in Oregon and Alaska. Mycologia 2011, 103, 22–35. [Google Scholar] [CrossRef] [PubMed]
- Yang, X.; Gallegly, M.E.; Hong, C. A high-temperature tolerant species in clade 9 of the genus Phytophthora: P. hydrogena sp. nov. Mycologia 2014, 106, 57–65. [Google Scholar] [CrossRef]
- Stamler, R.A.; Sanogo, S.; Goldberg, N.P.; Randall, J.J. Phytophthora Species in Rivers and Streams of the Southwestern United States. Appl. Environ. Microbiol. 2016, 82, 4696–4704. [Google Scholar] [CrossRef]
- Pintos, C.; Rial, C.; Aguín, O.; Ferreiroa, V.; Mansilla, J.P. First report of Phytophthora hydropathica in river water associated with riparian alder in Spain. New Dis. Rep. 2016, 33, 25. [Google Scholar] [CrossRef]
- Thines, M.; Kamoun, S. Oomycete-plant coevolution: Recent advances and future prospects. Curr. Opin. Plant Biol. 2010, 13, 1e7. [Google Scholar] [CrossRef]
- Redekar, N.R.; Eberhart, J.L.; Parke, J.L. Diversity of Phytophthora, Pythium, and Phytopythium Species in Recycled Irrigation Water in a Container Nursery. Phytobiomes J. 2019, 3, 31–45. [Google Scholar] [CrossRef]
- Govers, L.L.; Man in ‘t Veld, W.A.; Meffert, J.P.; Bouma, T.J.; van Rijswick, P.C.J.; Heusinkveld, J.H.T.; Orth, R.J.; van Katwijk, M.M.; van der Heide, T. Marine Phytophthora species can hamper conservation and restoration of vegetated coastal ecosystems. Proc. R. Soc. B 2016, 283, 20160812. [Google Scholar] [CrossRef]
- Bennett, R.M.; Thines, M. Confirmation that Phytophthora insolita (Peronosporaceae) is present as a marine saprotroph on mangrove leaves and first report of the species for the Philippines. Nova Hedwig. Band 2017, 105, 185–196. [Google Scholar] [CrossRef]
- Bennett, R.M.; Thines, M. An overview on Philippine estuarine oomycetes. Philipp. J. Syst. Biol. 2020, 14, 1–14. [Google Scholar]
- Kostov, K.; Christova, P.; Lyubenova, A.; Slavov, S. Diversity of oomycete species in the riparian ecosystem of Iskar gorge. Annual of Sofia University “St. Kliment Ohridski”. In Book 4—Scientific Sessions of the Faculty of Biology; Sofia University: Sofia, Bulgaria, 2019; Volume 104, pp. 90–99. [Google Scholar]
- Christova, P.K.; Lyubenova, A.B.; Kostov, K.V.; Slavov, S.B. First report of Phytophthora pseudosyringae recovered from aquatic ecosystems in Bulgaria. For. Pathol. 2019, 49, e12505. [Google Scholar] [CrossRef]
- Christova, P.K. Detection of Phytophthora gallica in Bulgaria and co-existence with other Phytophthora species in a small river. J. Plant Dis. Prot. 2022, 129, 1377–1387. [Google Scholar] [CrossRef]
- Christova, P.K. Phytophthora polonica and Phytophthora hydropathica from clade 9 associated with alder decline in Bulgaria. Life 2024, 14, 720. [Google Scholar] [CrossRef] [PubMed]
- Slavov, S.; Lubenova, A.; Kostov, K.; Christova, P. Oomycotes from genus Pythium found in water and soil samples in Bulgaria. J. Mt. Agric. Balk. 2018, 21, 161–171. [Google Scholar]
- Yordanova, E. First report of root rot caused by Pythium aphanidermatum on industrial hemp (Cannabis sativa L.) in Bulgaria. Agric. Sci. 2023, 15, 83–88. [Google Scholar] [CrossRef]
- Vatchev, T.D.; Bistrichanov, S.M.; Yanashkov, I.T. First report of root rot caused by Pythium aphanidermatum and Pythium F-group on hydroponically grown pepper in Bulgaria. Bulg. J. Agric. Sci. 2016, 22, 794–795. [Google Scholar]
- Nechwatal, J.; Bakonyi, J.; Cacciola, S.O.; Cooke, D.E.L.; Jung, T.; Nagy, Z.A.; Vannini, A.; Vettraino, A.M.; Brasier, C.M. The morphology, behavior and molecular phylogeny of Phytophthora taxon Salixsoil and its redestination as Phytophthora lacustris sp. nov. Plant Pathol. 2013, 62, 355–369. [Google Scholar] [CrossRef]
- Vitale, S.; Luongo, L.; Galli, M.; Belisario, A. A First Report of Phytophthora hydropathica Causing Wilting and Shoot Dieback on Viburnum in Italy. Plant Dis. 2014, 98, 1582. [Google Scholar] [CrossRef]
- Bregant, C.; Sanna, G.P.; Bottos, A.; Maddau, L.; Montecchio, L.; Linaldeddu, B.T. Diversity and pathogenicity of Phytophthora species associated with declining alder trees in Italy and description of Phytophthora alpina sp. nov. Forests 2020, 11, 84. [Google Scholar] [CrossRef]
- Hong, C.X.; Gallegly, M.E.; Richardson, P.A.; Kong, P.; Moorman, G.W.; Lea-Cox, J.D.; Ross, D.S. Phytophthora hydropathica, a new pathogen identified from irrigation water, Rhododendron catawbiense and Kalmia latifolia. Plant Pathol. 2010, 59, 913–921. [Google Scholar] [CrossRef]
- La Spada, F.; Cock, P.J.A.; Randall, E.; Pane, A.; Cooke, D.E.L.; Cacciola, S.O. DNA Metabarcoding and Isolation by Baiting Complement Each Other in Revealing Phytophthora Diversity in Anthropized and Natural Ecosystems. J. Fungi 2022, 8, 330. [Google Scholar] [CrossRef]
- Santilli, E.; Riolo, M.; La Spada, F.; Pane, A.; Cacciola, S.O. First Report of Root Rot Caused by Phytophthora bilorbang on Olea europaea in Italy. Plants 2020, 9, 826. [Google Scholar] [CrossRef] [PubMed]
- Bregant, C.; Mulas, A.A.; Rossetto, G.; Deidda, A.; Maddau, L.; Piras, G.; Linaldeddu, B.T. Phytophthora mediterranea sp. nov., a New Species Closely Related to Phytophthora cinnamomi from Nursery Plants of Myrtus communis in Italy. Forests 2021, 12, 682. [Google Scholar] [CrossRef]
- Aghighi, S.; Hardy, G.E.S.J.; Scott, J.K.; Burgess, T.I. Phytophthora bilorbang sp. nov., a new species associated with the decline of Rubus anglocandicans (European blackberry) in Western Australia. Eur. J. Plant Pathol. 2012, 133, 841–855. [Google Scholar] [CrossRef]
- Brasier, C.M.; Sanchez-Hernandez, E.; Kirk, S.A. Phytophthora inundata sp. nov., a part heterothallic pathogen of trees and shrubs in wet or flooded soils. Mycol. Res. 2003, 107, 477–484. [Google Scholar] [CrossRef] [PubMed]
- Ho, H.H.; Hong, C.X.; Erwin, D.C. Phytophthora inundata isolated from diseased alfalfa roots in southern California. Mycotaxon 2006, 97, 349–358. [Google Scholar]
- Safaiefarahani, B.; Mostowfizadeh-Ghalamfarsa, R.; Cooke, D.E.L. Characterisation of Phytophthora inundata according to host range, morphological variation and multigene molecular phylogeny. Phytopathol. Mediterr. 2013, 52, 46–65. [Google Scholar]
- Kurbetli, İ.; Sülü, G.; Taştekin, E.; Polat, İ. First report of Phytophthora inundata causing olive tree decline in Turkey. Can. J. Plant Pathol. 2016, 38, 254–257. [Google Scholar] [CrossRef]
- Kurbetli, İ.; Karaca, G.; Aydoğdu, M.; Sülü, G. Phytophthora Species Causing Root and Collar Rot of Pomegranate in Turkey. Eur. J. Plant Pathol. 2020, 157, 485–496. [Google Scholar] [CrossRef]
- Choudhary, C.E.; Burgos-Garay, M.L.; Moorman, G.W.; Hong, C. Pythium and Phytopythium species in two Pennsylvania greenhouse irrigation water tanks. Plant Dis. 2016, 100, 926–932. [Google Scholar] [CrossRef] [PubMed]
- Radmer, L.; Anderson, G.; Malvick, D.M.; Kurle, J.E.; Rendahl, A.; Mallik, A. Pythium, Phytophthora, and Phytopythium spp. associated with soybean in Minnesota, their relative aggressiveness on soybean and corn, and their sensitivity to seed treatment fungicides. Plant Dis. 2017, 101, 62–72. [Google Scholar] [CrossRef] [PubMed]
- Javadi, N.; Sharifnabi, B. Phytopythium litorale, the causal agent of almond root and crown rot in Iran. In Proceedings of the 22nd Iranian Plant Protection Congress, College of Agriculture and Natural Resources, University of Tehran, Karaj, Iran, 27–30 August 2016. [Google Scholar]
- Derviş, S.; Turkolmez, Ş.; Ciftci, O.; Ozer, G.; Serce, C.U.; Dikilitas, M. Phytopythium littorale: A novel killer pathogen of plane (Platanus orientalis) causing canker stain and root and collar rot. Plant Dis. 2020, 104, 2642–2648. [Google Scholar] [CrossRef] [PubMed]
- Cleary, M.; Blomquist, M.; Marchand, M.; Witzell, J. Oomycetes in rhizosphere soil of ornamental plants from retail nurseries in Southern Sweden. For. Pathol. 2021, 51, e12673. [Google Scholar] [CrossRef]
- Cordier, T.; Belbahri, L.; Calmin, G.; Oszako, T.; Nowakowska, J.; Lefort, F. Emerging Phytophthora and Pythium species in Polish declining forests. Established and emerging Phytophthora: Increasing threats to woodland and forest ecosystems in Europe. In Proceedings of the First Working Groups Meeting, Nový Smokovec, Slovakia, 16–19 April 2009. [Google Scholar]
- Jankowiak, R.; Stępniewska, H.; Bilański, P. Notes on some Phytopythium and Pythium species occurring in oak forests in southern Poland. Acta Mycologyca 2015, 50, 1052. [Google Scholar] [CrossRef]
- Sparrow, F.K. Two new species of Pythium parasitic in green algae. Ann. Bot. 1931, 45, 257–277. [Google Scholar] [CrossRef]
- Crocker, E.V.; Karp, M.A.; Nelson, E.B. Virulence of oomycete pathogens from Phragmites australis-invaded and noninvaded soils to seedlings of wetland plant species. Ecol. Evol. 2015, 5, 2127–2139. [Google Scholar] [CrossRef]
- Matsiakh, I.; Oszako, T.; Kramarets, V.; Nowakowska, J.A. Phytophthora and Pythium Species Detected in Rivers of the Polish-Ukrainian Border Areas. Balt. For. 2016, 22, 230–238. [Google Scholar]
- Oszako, T.; Sikora, K.; Belbahr, L.; Nowakowska, J.A. Molecular detection of oomycetes species in water courses. Folia For. Pol. Ser. A For. 2016, 58, 246–251. [Google Scholar] [CrossRef]
- Jung, T.; Blaschke, H.; Oßwald, W. Involvement of soilborne Phythophthora species in Central European oak decline and the effect of site factors on the disease. Plant Pathol. 2000, 49, 706–718. [Google Scholar] [CrossRef]
- Jönsson, U.; Lundberg, L.; Sonesson, K.; Jung, T. First records of soilborne Phytophthora species in Swedish oak forests. For. Pathol. 2003, 33, 175–179. [Google Scholar] [CrossRef]
- Balcì, Y.; Halmschlager, E. Incidence of Phytophthora species in oak forests in Austria and their possible involvement in oak decline. For. Pathol. 2003, 33, 157–174. [Google Scholar] [CrossRef]
- Balcì, Y.; Halmschlager, E. Phytophthora species in oak ecosystems in Turkey and their association with declining oak trees. Plant Pathololy 2003, 52, 694–702. [Google Scholar] [CrossRef]
- Akıllı, S.; Serçe, Ç.U.; Katırcıoğlu, Y.Z.; Maden, S. Does Pythium anandrum contribute to the dieback of sessile oak (Quercus petraea) in Turkey? For. Pathol. 2013, 43, 505–508. [Google Scholar] [CrossRef]

| Plant Species | Phytophthora | Phytopythium | Pythium | Elongisporangium | ||||||||||||
|---|---|---|---|---|---|---|---|---|---|---|---|---|---|---|---|---|
| 113d/PL | 119a/PB | 119b/PI | 120c/PH | 113a/PpC | 113b/PpL | 114c/PyAg | 115d/EAn | |||||||||
| Leaves/Cuttings | L | C | L | C | L | C | L | C | L | C | L | C | L | C | L | C |
| C. siliquastrum | +++ | +++ | + | ++ | - | + | +++ | +++ | + | +++ | ++ | +++ | - | + | - | + |
| Q. robur | +++ | +++ | + | + | + | + | +++ | +++ | ++ | +++ | +++ | ++ | + | + | + | + |
| P. tremula | +++ | +++ | ++ | ++ | - | - | +++ | +++ | +++ | +++ | +++ | +++ | - | - | + | + |
| S. babylonica | +++ | - | - | + | - | - | + | - | + | - | - | + | - | - | - | - |
| R. canina | +++ | +++ | - | - | - | + | +++ | +++ | + | ++ | ++ | +++ | - | - | + | - |
| R. fruticosus | - | - | - | - | - | - | - | - | - | - | - | - | - | - | - | - |
| H. helix | - | - | - | - | - | - | ++ | - | - | - | - | - | - | - | ++ | - |
| P. quinquefolia | +++ | + | + | - | ++ | - | ++ | ++ | +++ | ++ | +++ | + | + | - | - | - |
| C. vitalba | ++ | + | - | - | + | - | ++ | - | ++ | - | ++ | - | - | - | - | - |
| M. sativa | - | - | - | - | - | - | +++ | ++ | ++ | - | ++ | - | + | - | + | - |
| T. repens | + | na | + | na | ++ | na | +++ | na | - | na | ++ | na | - | na | ++ | na |
| P. lanceolata | - | na | ++ | na | +++ | na | + | na | ++ | na | - | na | ++ | na | - | na |
| P. major | - | na | - | na | - | na | + | na | - | na | - | na | - | na | - | na |
| B. perennis | ++ | na | ++ | na | + | na | ++ | na | - | na | ++ | na | ++ | na | - | na |
| A. millefolium | ++ | na | + | na | ++ | na | + | na | ++ | na | ++ | na | ++ | na | - | na |
| S. viridis | ++ | na | - | na | + | na | - | na | ++ | na | + | na | - | na | + | na |
Disclaimer/Publisher’s Note: The statements, opinions and data contained in all publications are solely those of the individual author(s) and contributor(s) and not of MDPI and/or the editor(s). MDPI and/or the editor(s) disclaim responsibility for any injury to people or property resulting from any ideas, methods, instructions or products referred to in the content. |
© 2024 by the author. Licensee MDPI, Basel, Switzerland. This article is an open access article distributed under the terms and conditions of the Creative Commons Attribution (CC BY) license (https://creativecommons.org/licenses/by/4.0/).
Share and Cite
Christova, P.K. Fishing for Estuarine Oomycetes. Diversity 2024, 16, 530. https://doi.org/10.3390/d16090530
Christova PK. Fishing for Estuarine Oomycetes. Diversity. 2024; 16(9):530. https://doi.org/10.3390/d16090530
Chicago/Turabian StyleChristova, Petya Koeva. 2024. "Fishing for Estuarine Oomycetes" Diversity 16, no. 9: 530. https://doi.org/10.3390/d16090530
APA StyleChristova, P. K. (2024). Fishing for Estuarine Oomycetes. Diversity, 16(9), 530. https://doi.org/10.3390/d16090530
